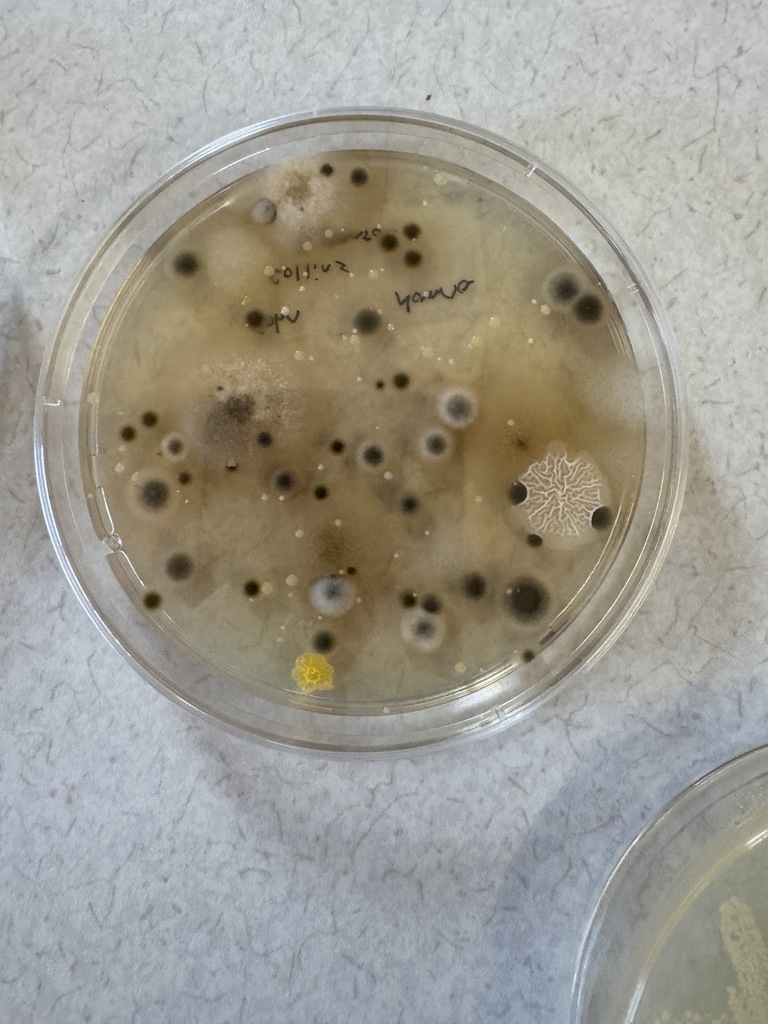

Mr. Nanna and Ms. Palmer’s sixth graders are learning about bacteria by collecting samples from surfaces around the school. Students then used digital microscopes on their Chromebooks to discover what they found!🦠

"On Wednesdays, we wear PINK!" 🩷 In honor of October being #breastcancerawarenessmonth, staff members at our Rossler location wore pink today.


Support the varsity soccer team throughout the month of October! The Falcons play at Central Baptist Christian School tomorrow at 4:00 p.m.


Mr. Steinberg brought the classroom outdoors to study the trees on the Cambridge grounds. 🌳 Students learned about different types of trees and the characteristics of their leaves, bark and seeds.


Our third graders had bushels of fun going apple picking this week! 🍎🍏









Happy first day of fall! 🍂🍁 Mullen students and staff members celebrated with apple cider and donuts!








The "Book Fairy" visited Ms. Fedeson and Mr. Marzullo's classroom and left behind a messy, yet fun surprise! Each student received a book, encouraging them to continue working towards their reading goals and discover a new adventure within each page.





The Falcons fought hard in their first varsity soccer game against Central Baptist Christian School. Despite the 5-2 loss, sophomore Justin Ruiz (6) scored both goals and the team showed great determination from start to finish. Let’s go, Falcons! 💙










The varsity soccer season kicks off this week! ⚽ Come support our Cambridge and Rossler athletes as they take on Central Baptist Christian School tomorrow at 4:00 p.m.! View the full schedule on our website.


Mr. Bystrak, Mrs. Federio, Ms. O'Neal and Ms. Arrington-Barton worked together to transform the classroom into a courtroom and assigned students roles in a mock trial complete with a jury to help them learn about the justice system. Through writing statements, presenting cases and deliberating as jurors, students gained insight into how different perspectives can influence a verdict.







Cambridge's Deli-licious Academy is back in business for the 2025-2026 school year! Students served up quesadillas, rice, refried beans and flan yesterday for Hispanic Heritage Month. We can't wait to see what our students cook up this year in the deli!


@djmilkbuffalo and @therealdjyes hyped up the hallways this morning at Mullen with a mobile DJ! Thank you for kicking off the school year with us! ❤️💙






A huge THANK YOU to @djmilkbuffalo and @therealdjyes , the official DJs of the @buffalobills for bringing the energy to our Roosevelt campus! ❤️💙 It was the best way to celebrate #victorymonday and a new school year!







Week 1 ✅
#backtoschool
#backtoschool


Happy first day to all our students and staff members! We wish you much success for the 2025-2026 school year! 🍎📓✏️



Flashback Friday to last year's first day of school! Five more days until we welcome our students back to the classroom! 🎉










Please join us in congratulating Mrs. Chenez on her transition to Cambridge's Assistant Principal!
Over the past 8 years, Mrs. Chenez has held multiple positions at Falk School including teacher’s aide, substitute teacher, school counselor, athletic coordinator and teacher on special assignment (TOSA). Her hard work, dedication and compassion have been nothing short of inspiring. We couldn't be more excited for this next chapter!
"I'm truly honored to step into a new role at a school that means so much to me," said Mrs. Chenez. "I'm looking forward to a new school year full of growth, positivity and purpose!"
Congratulations, Mrs. Chenez! We can't wait to see you shine in this new role!
Over the past 8 years, Mrs. Chenez has held multiple positions at Falk School including teacher’s aide, substitute teacher, school counselor, athletic coordinator and teacher on special assignment (TOSA). Her hard work, dedication and compassion have been nothing short of inspiring. We couldn't be more excited for this next chapter!
"I'm truly honored to step into a new role at a school that means so much to me," said Mrs. Chenez. "I'm looking forward to a new school year full of growth, positivity and purpose!"
Congratulations, Mrs. Chenez! We can't wait to see you shine in this new role!


Mullen students participated in a "Biome Bonanza" to celebrate the second last day of the summer program! Staff members planned multiple biome-themed activities like mountain building, Savanna animal hunt and rainforest relay!










During Cambridge's 24th annual luau week, staff members coupled up for a water balloon toss! Congratulations to Ms. Daniels and Mr. Rainey on being the last team standing and winning Amazon gift cards!









Thank you WNY Tiny Petting Zoo for visiting our Roosevelt campus last week! Students were able to pet and interact with lots of furry and feathered friends! 🦆🐐🐰 We hope to see you again soon!









